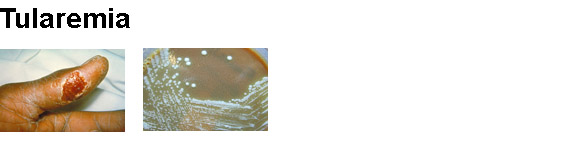

<<BACK
Tularemia
Fact sheet - En
Español
Tularemia Fact sheet
Bioterrorism Poster - PDF
CDC: Tularemia
CDC: Key Facts About Tularemia - En Español
CDC: Frequently Asked Questions (FAQ) About Tularemia - En Español
Liquid Ciprofloxacin for infants and children exposed to a disease - PDF [Video]
Liquid Doxycycline for infants and children exposed to a disease - PDF [Video]